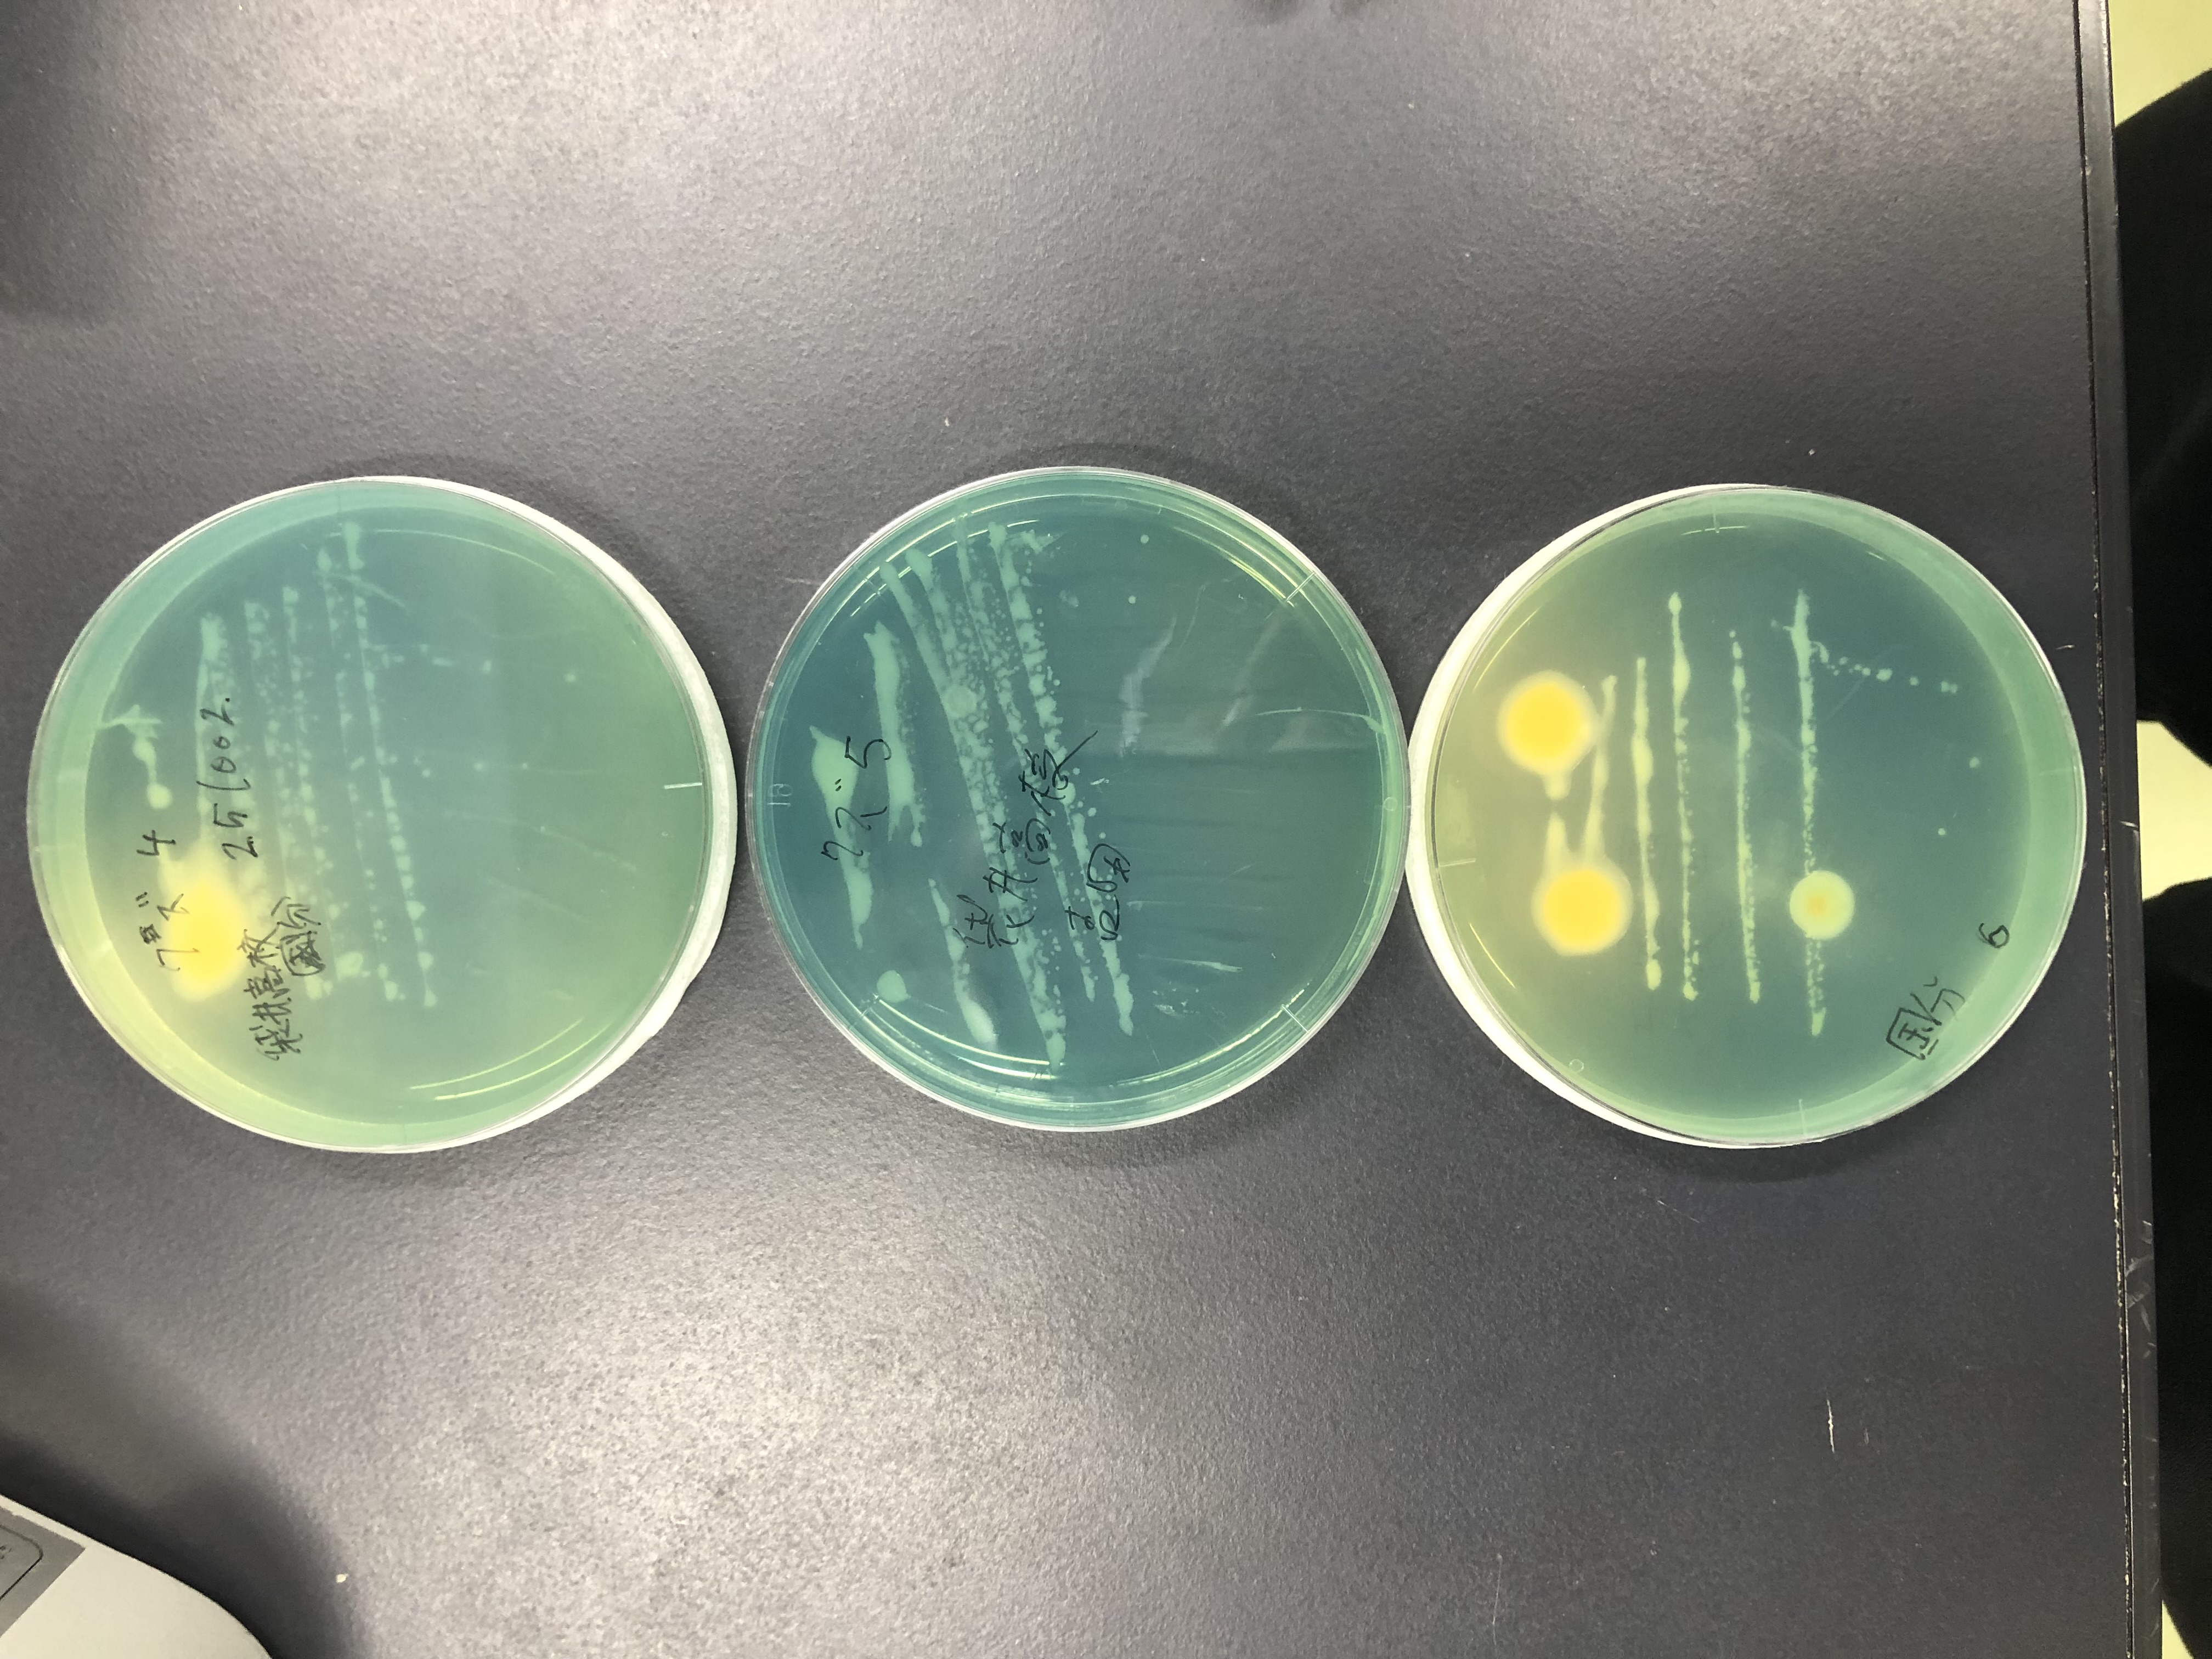

齋藤研究室の活動
2026年度

2026年6月9日
星陵祭(星陵高等学校)で出展しました!!
パン酵母、納豆菌、コウジカビのコロニーの形を見てもらったり、匂いをかいでみてもらったりしました。
高校生だけでなく、小学生や保護者の方まで、いろいろな方が、パン酵母のパンの匂いに驚いたり、喜んだりしてくれました。
本学OBも複数訪ねてくれました。
訪問くださった皆さん、星陵高校のみなさん、本学の関係者の皆さん、貴重な機会をありがとうございました!
Instagramへのリンク
星陵祭(星陵高等学校)で出展しました!!
パン酵母、納豆菌、コウジカビのコロニーの形を見てもらったり、匂いをかいでみてもらったりしました。
高校生だけでなく、小学生や保護者の方まで、いろいろな方が、パン酵母のパンの匂いに驚いたり、喜んだりしてくれました。
本学OBも複数訪ねてくれました。
訪問くださった皆さん、星陵高校のみなさん、本学の関係者の皆さん、貴重な機会をありがとうございました!
Instagramへのリンク

2026年6月2日
日本土壌微生物学会 市民公開シンポジウム 参加者募集!!
齋藤教授が実行委員長を務める日本土壌微生物学会2026年度大会(静岡)の会期中に、市民公開シンポジウム(主催 日本土壌微生物学会/ 後援 静岡理工科大学・静岡大学)が開催されます。
参加無料です。
インスタはこちら
日本土壌微生物学会 市民公開シンポジウム 参加者募集!!
齋藤教授が実行委員長を務める日本土壌微生物学会2026年度大会(静岡)の会期中に、市民公開シンポジウム(主催 日本土壌微生物学会/ 後援 静岡理工科大学・静岡大学)が開催されます。
参加無料です。
インスタはこちら

2026年6月2日
研究室のインスタを始めました。
名前は「静岡理工科大学 応用微生物学研究室」、ユーザー名は「oubi_sist」です。
https://www.instagram.com/oubi_sist
今後、このページの記事は、インスタへリンクする形式にしていきます。
研究室のインスタを始めました。
名前は「静岡理工科大学 応用微生物学研究室」、ユーザー名は「oubi_sist」です。
https://www.instagram.com/oubi_sist
今後、このページの記事は、インスタへリンクする形式にしていきます。
2025年度

2026年3月14日
3月14日(土)に、大学の卒業式と大学院の修了式が挙行されました。
卒業、終了の皆さん、おめでとうございます!
大学院に進学する野田さんが、卒業研究発表で、優秀発表賞を受賞しました!
あわせておめでとうございます!
3月14日(土)に、大学の卒業式と大学院の修了式が挙行されました。
卒業、終了の皆さん、おめでとうございます!
大学院に進学する野田さんが、卒業研究発表で、優秀発表賞を受賞しました!
あわせておめでとうございます!
2026年3月12日
3月8日(日)に、静岡駅前キャンパスM20を会場として、第26回静岡ライフサイエンスシンポジウムが開催され、研究室の鈴木琉太さん(M2)と野田真之介さん(B4)がポスター発表しました。鈴木琉太さんは、ポスター発表(大学院生の部)で優秀ポスター賞を受賞しました。そのほか、私たちの研究室と共同研究をしている小土橋研究室の大学院生のが最優秀ポスター賞と優秀ポスター賞をそれぞれ受賞するなど、理工科大学の学生・大学院生が活躍しました。
受賞なさった皆さん、おめでとうございます!
また、当日は、共同研究をしている小土橋教授がシンポジストとして登壇したほか、齋藤教授は実行委員長として運営に関わりました。
#静岡理工科大学
#小土橋陽平
#齋藤明広
3月8日(日)に、静岡駅前キャンパスM20を会場として、第26回静岡ライフサイエンスシンポジウムが開催され、研究室の鈴木琉太さん(M2)と野田真之介さん(B4)がポスター発表しました。鈴木琉太さんは、ポスター発表(大学院生の部)で優秀ポスター賞を受賞しました。そのほか、私たちの研究室と共同研究をしている小土橋研究室の大学院生のが最優秀ポスター賞と優秀ポスター賞をそれぞれ受賞するなど、理工科大学の学生・大学院生が活躍しました。
受賞なさった皆さん、おめでとうございます!
また、当日は、共同研究をしている小土橋教授がシンポジストとして登壇したほか、齋藤教授は実行委員長として運営に関わりました。
#静岡理工科大学
#小土橋陽平
#齋藤明広




2026年2月17日
大学院修士課程2年の鈴木琉太さんが、本学の奨励賞を受賞しました。
写真左は、学長から賞状と副賞が授与されるときの様子です。
2025年6月に開催された日本土壌微生物学会2025年度大会(土浦)で優秀ポスター賞を受賞することで、本学の知名度を高めたことに対する表彰です。
鈴木琉太さん、おめでとうございます!
なお、鈴木さんと同じ材料科学専攻に属する他の研究室の大学院生6名も同時に、奨励賞を受賞しました。
みなさんおめでとうございます。
様々な学会等の年次大会(国際会議を含む)で優秀な発表をして表彰されたり、日本学術振興会のDC1に採用されたりと、皆さん活躍していてすばらしいです。
大学院修士課程2年の鈴木琉太さんが、本学の奨励賞を受賞しました。
写真左は、学長から賞状と副賞が授与されるときの様子です。
2025年6月に開催された日本土壌微生物学会2025年度大会(土浦)で優秀ポスター賞を受賞することで、本学の知名度を高めたことに対する表彰です。
鈴木琉太さん、おめでとうございます!
なお、鈴木さんと同じ材料科学専攻に属する他の研究室の大学院生6名も同時に、奨励賞を受賞しました。
みなさんおめでとうございます。
様々な学会等の年次大会(国際会議を含む)で優秀な発表をして表彰されたり、日本学術振興会のDC1に採用されたりと、皆さん活躍していてすばらしいです。


2026年1月9日
齋藤教授が公益社団法人 ヤンマー資源循環支援機構の2025年度研究助成者交流会に出席しました。
第12回 2025年度の研究助成を受けて実施している研究課題の進捗状況を報告するとともに、同助成を受けている国内の他の研究者や大学院生の研究を知り、人的交流を深めました。
大変貴重な機会をありがとうございました。
齋藤教授が公益社団法人 ヤンマー資源循環支援機構の2025年度研究助成者交流会に出席しました。
第12回 2025年度の研究助成を受けて実施している研究課題の進捗状況を報告するとともに、同助成を受けている国内の他の研究者や大学院生の研究を知り、人的交流を深めました。
大変貴重な機会をありがとうございました。

交流会の会場となったヤンマーホールディングス(株)の本社

交流会の受付付近にあった企業キャラクター「ヤン坊マー坊」
2025年10月2日
6月に引き続き静岡県立袋井高等学校の生徒さんが本学に見学にいらっしゃいました。
微生物に興味のある生徒さん2名が、応用微生物学研究室を見学に来られました。
6月に見学に来た生徒さんが調製した寒天培地に、大学構内に生息するマメ科植物の根粒の中身を植菌してもらいました。
以下の写真は、植菌後に30℃で培養して生じたコロニーです。
これらの微生物はいったい何者なのか?
齋藤教授が講義や会議の合間に実験しています。
同様の見学を高校でご検討なさっている場合には、本学入試広報推進課までご相談ください。
6月に引き続き静岡県立袋井高等学校の生徒さんが本学に見学にいらっしゃいました。
微生物に興味のある生徒さん2名が、応用微生物学研究室を見学に来られました。
6月に見学に来た生徒さんが調製した寒天培地に、大学構内に生息するマメ科植物の根粒の中身を植菌してもらいました。
以下の写真は、植菌後に30℃で培養して生じたコロニーです。
これらの微生物はいったい何者なのか?
齋藤教授が講義や会議の合間に実験しています。
同様の見学を高校でご検討なさっている場合には、本学入試広報推進課までご相談ください。
大学構内に自生するマメ科植物の根粒から分離された微生物の様子
2025年9月17~19日
日本土壌肥料学会2025年度新潟大会(新潟大学五十嵐キャンパス)、に齋藤教授が参加し、研究成果を口頭発表しました。
(日本土壌肥料学会のHPはこちら)
齋藤教授は第3部門(土壌生物部門)の副部門長としての役目も務めました。
次年度大会は福島だそうです!
日本土壌肥料学会2025年度新潟大会(新潟大学五十嵐キャンパス)、に齋藤教授が参加し、研究成果を口頭発表しました。
(日本土壌肥料学会のHPはこちら)
齋藤教授は第3部門(土壌生物部門)の副部門長としての役目も務めました。
次年度大会は福島だそうです!

画像説明文

「いろいろな日本の土壌」(展示物)
2025年9月3~4日
2025年度(第39回)日本放線菌学会大会 静岡、に齋藤教授が参加し、研究成果を口頭発表しました。
(日本放線菌学会のHPはこちら)
齋藤教授は同大会の実行委員も務めました。研究室の4年生2名(長倉さんと野田さん)も大会運営に貢献しました。
次年度大会は東京(学習院大学)だそうです!
2025年度(第39回)日本放線菌学会大会 静岡、に齋藤教授が参加し、研究成果を口頭発表しました。
(日本放線菌学会のHPはこちら)
齋藤教授は同大会の実行委員も務めました。研究室の4年生2名(長倉さんと野田さん)も大会運営に貢献しました。
次年度大会は東京(学習院大学)だそうです!


2025年8月6日
静岡県立榛原高等学校の理数科の2年生の生徒さんが対象の理科実験講座を「自分の細胞からDNAをとってみよう!」と題して担当しました。
齋藤教授が講師を務め、研究室の4年生、大学院生、そして、榛原高校出身の物質生命科学科3年生の学生1名がアシスタントを務めました。
高校の生物基礎で学ぶ動物細胞の構造と生体膜・染色体を構成する物質について復習をしてから、細胞からDNAをとるにはどうしたらよいか皆で考え、そのうえで、自身の口腔上皮細胞を採取して、DNAを抽出しました。
抽出したDNAはペンダントにしました。
本実験の内容は、本学が提供する「出張・体験講義一覧」に含まれています。
同様の出張・体験講義をご希望なさる場合は、入試広報推進課あるいは社会連携課へご相談ください。
静岡県立榛原高等学校の理数科の2年生の生徒さんが対象の理科実験講座を「自分の細胞からDNAをとってみよう!」と題して担当しました。
齋藤教授が講師を務め、研究室の4年生、大学院生、そして、榛原高校出身の物質生命科学科3年生の学生1名がアシスタントを務めました。
高校の生物基礎で学ぶ動物細胞の構造と生体膜・染色体を構成する物質について復習をしてから、細胞からDNAをとるにはどうしたらよいか皆で考え、そのうえで、自身の口腔上皮細胞を採取して、DNAを抽出しました。
抽出したDNAはペンダントにしました。
本実験の内容は、本学が提供する「出張・体験講義一覧」に含まれています。
同様の出張・体験講義をご希望なさる場合は、入試広報推進課あるいは社会連携課へご相談ください。
2025年7月31日
本学が所属する学校法人(学校法人静岡理工科大学)の系列高校である、静岡北高等学校が主催するSKYSEFに、口頭発表審査員として齋藤教授が出席しました。SKYSEFは、Shizuoka Kita Youth Science Engineering Forumの略で、21世紀における持続可能な社会や環境のあり方について、中高生が主体的に議論することを目的とした国際フォーラムです(出典 静岡北高校HP)。
台湾、タイ、日本、の各国の高校生による興味深い発表がありました。
齋藤教授を含め、静岡理工科大学には、SKYSEF(英語による研究発表)のみならず、国内の高校で行われる課題研究発表会(日本語による研究発表)におけるコメンテーターや審査の経験をした教員が多々おります。
同様の業務以来のご相談、お申し込みは、本学入試広報推進課までお願いいたします。
本学が所属する学校法人(学校法人静岡理工科大学)の系列高校である、静岡北高等学校が主催するSKYSEFに、口頭発表審査員として齋藤教授が出席しました。SKYSEFは、Shizuoka Kita Youth Science Engineering Forumの略で、21世紀における持続可能な社会や環境のあり方について、中高生が主体的に議論することを目的とした国際フォーラムです(出典 静岡北高校HP)。
台湾、タイ、日本、の各国の高校生による興味深い発表がありました。
齋藤教授を含め、静岡理工科大学には、SKYSEF(英語による研究発表)のみならず、国内の高校で行われる課題研究発表会(日本語による研究発表)におけるコメンテーターや審査の経験をした教員が多々おります。
同様の業務以来のご相談、お申し込みは、本学入試広報推進課までお願いいたします。
2025年7月16日
本学を見学しに来てくれた静岡県立浜松工業高等学校システム化学科の生徒さんたちに対して、説明ブースを設け、研究内容を紹介しました。
本研究室の野田君(4年生)は、ガスクロマトグラフを用いた分析について、実演をしつつ、生徒さんたちに説明をしました。
生徒さんたちのアンケートを拝見したところ、農業と化学の接点を中心とした説明が好評だったようで、うれしかったです。
同様の見学のご相談、お申し込みは、本学入試広報推進課までお願いします。
本学を見学しに来てくれた静岡県立浜松工業高等学校システム化学科の生徒さんたちに対して、説明ブースを設け、研究内容を紹介しました。
本研究室の野田君(4年生)は、ガスクロマトグラフを用いた分析について、実演をしつつ、生徒さんたちに説明をしました。
生徒さんたちのアンケートを拝見したところ、農業と化学の接点を中心とした説明が好評だったようで、うれしかったです。
同様の見学のご相談、お申し込みは、本学入試広報推進課までお願いします。
2025年7月10日
齋藤教授が、静岡県立御殿場南高校で、「好奇心で始まるサイエンス:微生物研究を例に」と題して、模擬講義をしてきました。冒頭に、高校で学ぶ化学を大学で専攻して学ぶには、どのような学部や学科の選択肢があるのか、を紹介し、その後に、齋藤の研究実績の中から、純粋な真理探究型の研究成果を抜き出して、紹介しました。
同様の講義のご興味のある方は、本学入試広報推進課までご相談、お申し込みください。
齋藤教授が、静岡県立御殿場南高校で、「好奇心で始まるサイエンス:微生物研究を例に」と題して、模擬講義をしてきました。冒頭に、高校で学ぶ化学を大学で専攻して学ぶには、どのような学部や学科の選択肢があるのか、を紹介し、その後に、齋藤の研究実績の中から、純粋な真理探究型の研究成果を抜き出して、紹介しました。
同様の講義のご興味のある方は、本学入試広報推進課までご相談、お申し込みください。
2025年6月27日
静岡県立袋井高等学校の生徒さんが本学に見学にいらっしゃいました。
同日の様子は、本学のInstagramでも動画で紹介されています。
微生物に興味のある生徒さんが、応用微生物学研究室を見学に来られました。
寒天培地づくりも経験してもらいました。上記のInstagramの動画の最後の方にその様子が映っていますが、以下は応用微生物学研究室(齋藤研究室)に特化したものですので、ぜひご覧ください(本学入試広報推進課提供)。
同様の見学を高校でご検討なさっている場合には、本学入試広報推進課までご相談ください。
静岡県立袋井高等学校の生徒さんが本学に見学にいらっしゃいました。
同日の様子は、本学のInstagramでも動画で紹介されています。
微生物に興味のある生徒さんが、応用微生物学研究室を見学に来られました。
寒天培地づくりも経験してもらいました。上記のInstagramの動画の最後の方にその様子が映っていますが、以下は応用微生物学研究室(齋藤研究室)に特化したものですので、ぜひご覧ください(本学入試広報推進課提供)。
同様の見学を高校でご検討なさっている場合には、本学入試広報推進課までご相談ください。
2025年6月18日
今年もMetaSUBのサンプリングに参加しました!
今年度のグローバルサンプリングデーは6月20日(金)ですが、学生さんたちの都合で2日早くサンプリングしました。
齋藤教授が担当する講義「環境微生物学」の受講者である物質生命科学科バイオ食品科学コースの3年生の有志5名が、JR愛野駅前と本学のバス停付近でサンプリングしました。
#MetaSUB2025
今年もMetaSUBのサンプリングに参加しました!
今年度のグローバルサンプリングデーは6月20日(金)ですが、学生さんたちの都合で2日早くサンプリングしました。
齋藤教授が担当する講義「環境微生物学」の受講者である物質生命科学科バイオ食品科学コースの3年生の有志5名が、JR愛野駅前と本学のバス停付近でサンプリングしました。
#MetaSUB2025
ーーーーーーーーーーーーーーーーーーーーーーーーーーーーーーーーーーーーーーーーーーーーーーーーーーーーーーー
2025年6月14日
日本土壌微生物学会2025年度大会(茨城県土浦市)で、研究室の大学院生の鈴木琉太さんが以下のポスター発表で、優秀ポスター賞を受賞しました。おめでとうございます!鈴木琉太さんは土壌微生物学会大会での優秀ポスター賞は2年連続です。
発表タイトル:キチン分解における土壌細菌間クロスフィーディング:キチン非分解細菌 Ensifer sp. 5-50 株のチアミン生産能とチアミン要求性キチン分解細菌Agromyces sp. 5-23株のゲノム解析
発表者:〇鈴木琉太(静岡理工科大学)、道羅英夫(静岡大学)、森内良太(静岡大学)、齋藤明広(静岡理工科大学)
日本土壌微生物学会2025年度大会(茨城県土浦市)で、研究室の大学院生の鈴木琉太さんが以下のポスター発表で、優秀ポスター賞を受賞しました。おめでとうございます!鈴木琉太さんは土壌微生物学会大会での優秀ポスター賞は2年連続です。
発表タイトル:キチン分解における土壌細菌間クロスフィーディング:キチン非分解細菌 Ensifer sp. 5-50 株のチアミン生産能とチアミン要求性キチン分解細菌Agromyces sp. 5-23株のゲノム解析
発表者:〇鈴木琉太(静岡理工科大学)、道羅英夫(静岡大学)、森内良太(静岡大学)、齋藤明広(静岡理工科大学)
![]()
ーーーーーーーーーーーーーーーーーーーーーーーーーーーーーーーーーーーーーーーーーーーーーーーーーーーーーーー
2025年6月12日
袋井地域の茶生産者さんの茶園の土壌の採取を行いました。
採取後にはおいしいお茶をごちそうになりました。
おいしいお茶が栽培される土壌の秘密に迫るべく、これから分析をします。
袋井地域の茶生産者さんの茶園の土壌の採取を行いました。
採取後にはおいしいお茶をごちそうになりました。
おいしいお茶が栽培される土壌の秘密に迫るべく、これから分析をします。


| 日付 | 内容 |
| 2025年3月1日 | 大学院生の佐々木さんと鈴木さんが第25回静岡ライフサイエンスシンポジウムでポスター発表しました。鈴木さんの発表は、最優秀ポスター賞に選ばれました。 |
| 2024年10月28-29日 | 大学院生の佐々木さんと牧野さん、が日本微生物生態学会第37回広島大会に出席し、それぞれポスター発表しました。 |
| 2024年6月25日 | 今年もMetaSUBのサンプリングに参画しました! MetaSUBのグローバルシティサンプリングデーには遅れましたが、「環境微生物学」を履修する学生有志6名と齋藤研の研究室のメンバーで、毎年同様、愛野駅前と本学のバス停付近で、サンプリングしました。サンプルは国内取りまとめの鈴木治夫先生(慶応大学)のもとに送られ、一部は国内で、残りはアメリカで解析される予定です。#MetaSUB #gCSD2024 |
| 2024年6月16日 | 日本土壌微生物学会2024年度大会(名古屋大会)で大学院生の鈴木琉太さんが優秀ポスター賞を受賞しました。 |
| 2024年3月16日 | 大学卒業(4名)、大学院修士課程修了(2名)、おめでとうございます! 卒業研究発表会では、近藤さんと鈴木君が優秀発表賞を受賞しました。こちらもおめでとうございます! |
| 2023年12月22日 | 研究室で中間発表会を開催しました。 |
| 2023年11月28‐30日 | 大学院生の窪田さんと中村さん、齋藤教授が日本微生物生態学会第36回浜松大会に出席し、それぞれポスター発表しました。齋藤教授は大会実行委員も務めました。 |
| 2023年10月30日 | 飛龍高校(静岡県沼津市)の生徒さんが来学し微生物実験体験をしました。 |
| 2023年9月12日 | 齋藤教授が日本土壌肥料学会2023年度愛媛大会に出席し、口頭発表しました。 |
| 2023年6月21日 | 日本土壌微生物学会2023年度大会で中村さんが優秀学生発表賞を受賞 |
| 2023年6月21日 | 今年もMetaSUBに参加しました! |
| 2022年7月25日 | 静岡県立磐田南高等学校で出張講義 |
| 2022年7月14日 | ミニ課題研究発表会 |
| 2022年7月5日 | MetaSUBに今年も参加しています! |
| 2022年3月12日 | 令和3年度の卒業式・修了式 |
| 2022年2月17日 | 研究室の紹介記事がキャンパスニュースに掲載されました。 |
| 2021年6月24日 | MetaSUB2021に参画しました! |
| 2021年5月7日 | 齋藤明広教授が著書として貢献した土壌微生物学の書籍が発売されました。 |
| 2021年3月15日 | 2020年度卒業式 |
| 2021年3月15日 | アグリニクス研究会講演会・成果報告会 |